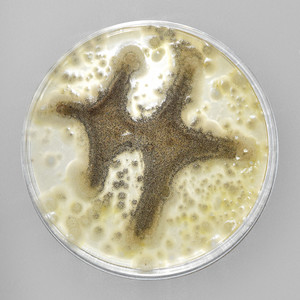
Hands On My Hips Like A Sheriff (Explicit)

Ruby Red
热门歌曲
-
-
Shopboy Fat、Ruby Red 3.14 MB 03:25
-
Hex Cougar、Ruby Red 3.47 MB 03:47
-
Ruby Red、the Moonshine Brothers 3.11 MB 03:23
-
Ruby Red 3.64 MB 03:58
-
Ruby Red 2.88 MB 03:08
-
Ruby Red、the Moonshine Brothers 3.25 MB 03:32
-
Ruby Red、the Moonshine Brothers 4.17 MB 04:33
-
Ruby Red 3.96 MB 04:19
-
Ruby Red 2.73 MB 02:59
-
Ruby Red 4.53 MB 04:57
-
Ruby Red 3.82 MB 04:10
-
Ruby Red 2.59 MB 02:49
-
Ruby Red 2.64 MB 02:52
-
Trap Heffner、Ruby Red 4.04 MB 04:24
-
Trap Heffner、Ruby Red 2.69 MB 02:56
-
Trap Heffner、Ruby Red 1.73 MB 01:53
-
SugarBeats、Ruby Red 3.84 MB 04:11
-
Ruby Red 3.08 MB 03:21
-
Ruby Red 3.97 MB 04:20
-
Ruby Red 3.34 MB 03:38
-
Ruby Red 3.08 MB 03:21
-
-
Ruby Red 2.84 MB 03:06
-
-
Raven Artson、Ruby Red 2.78 MB 03:01